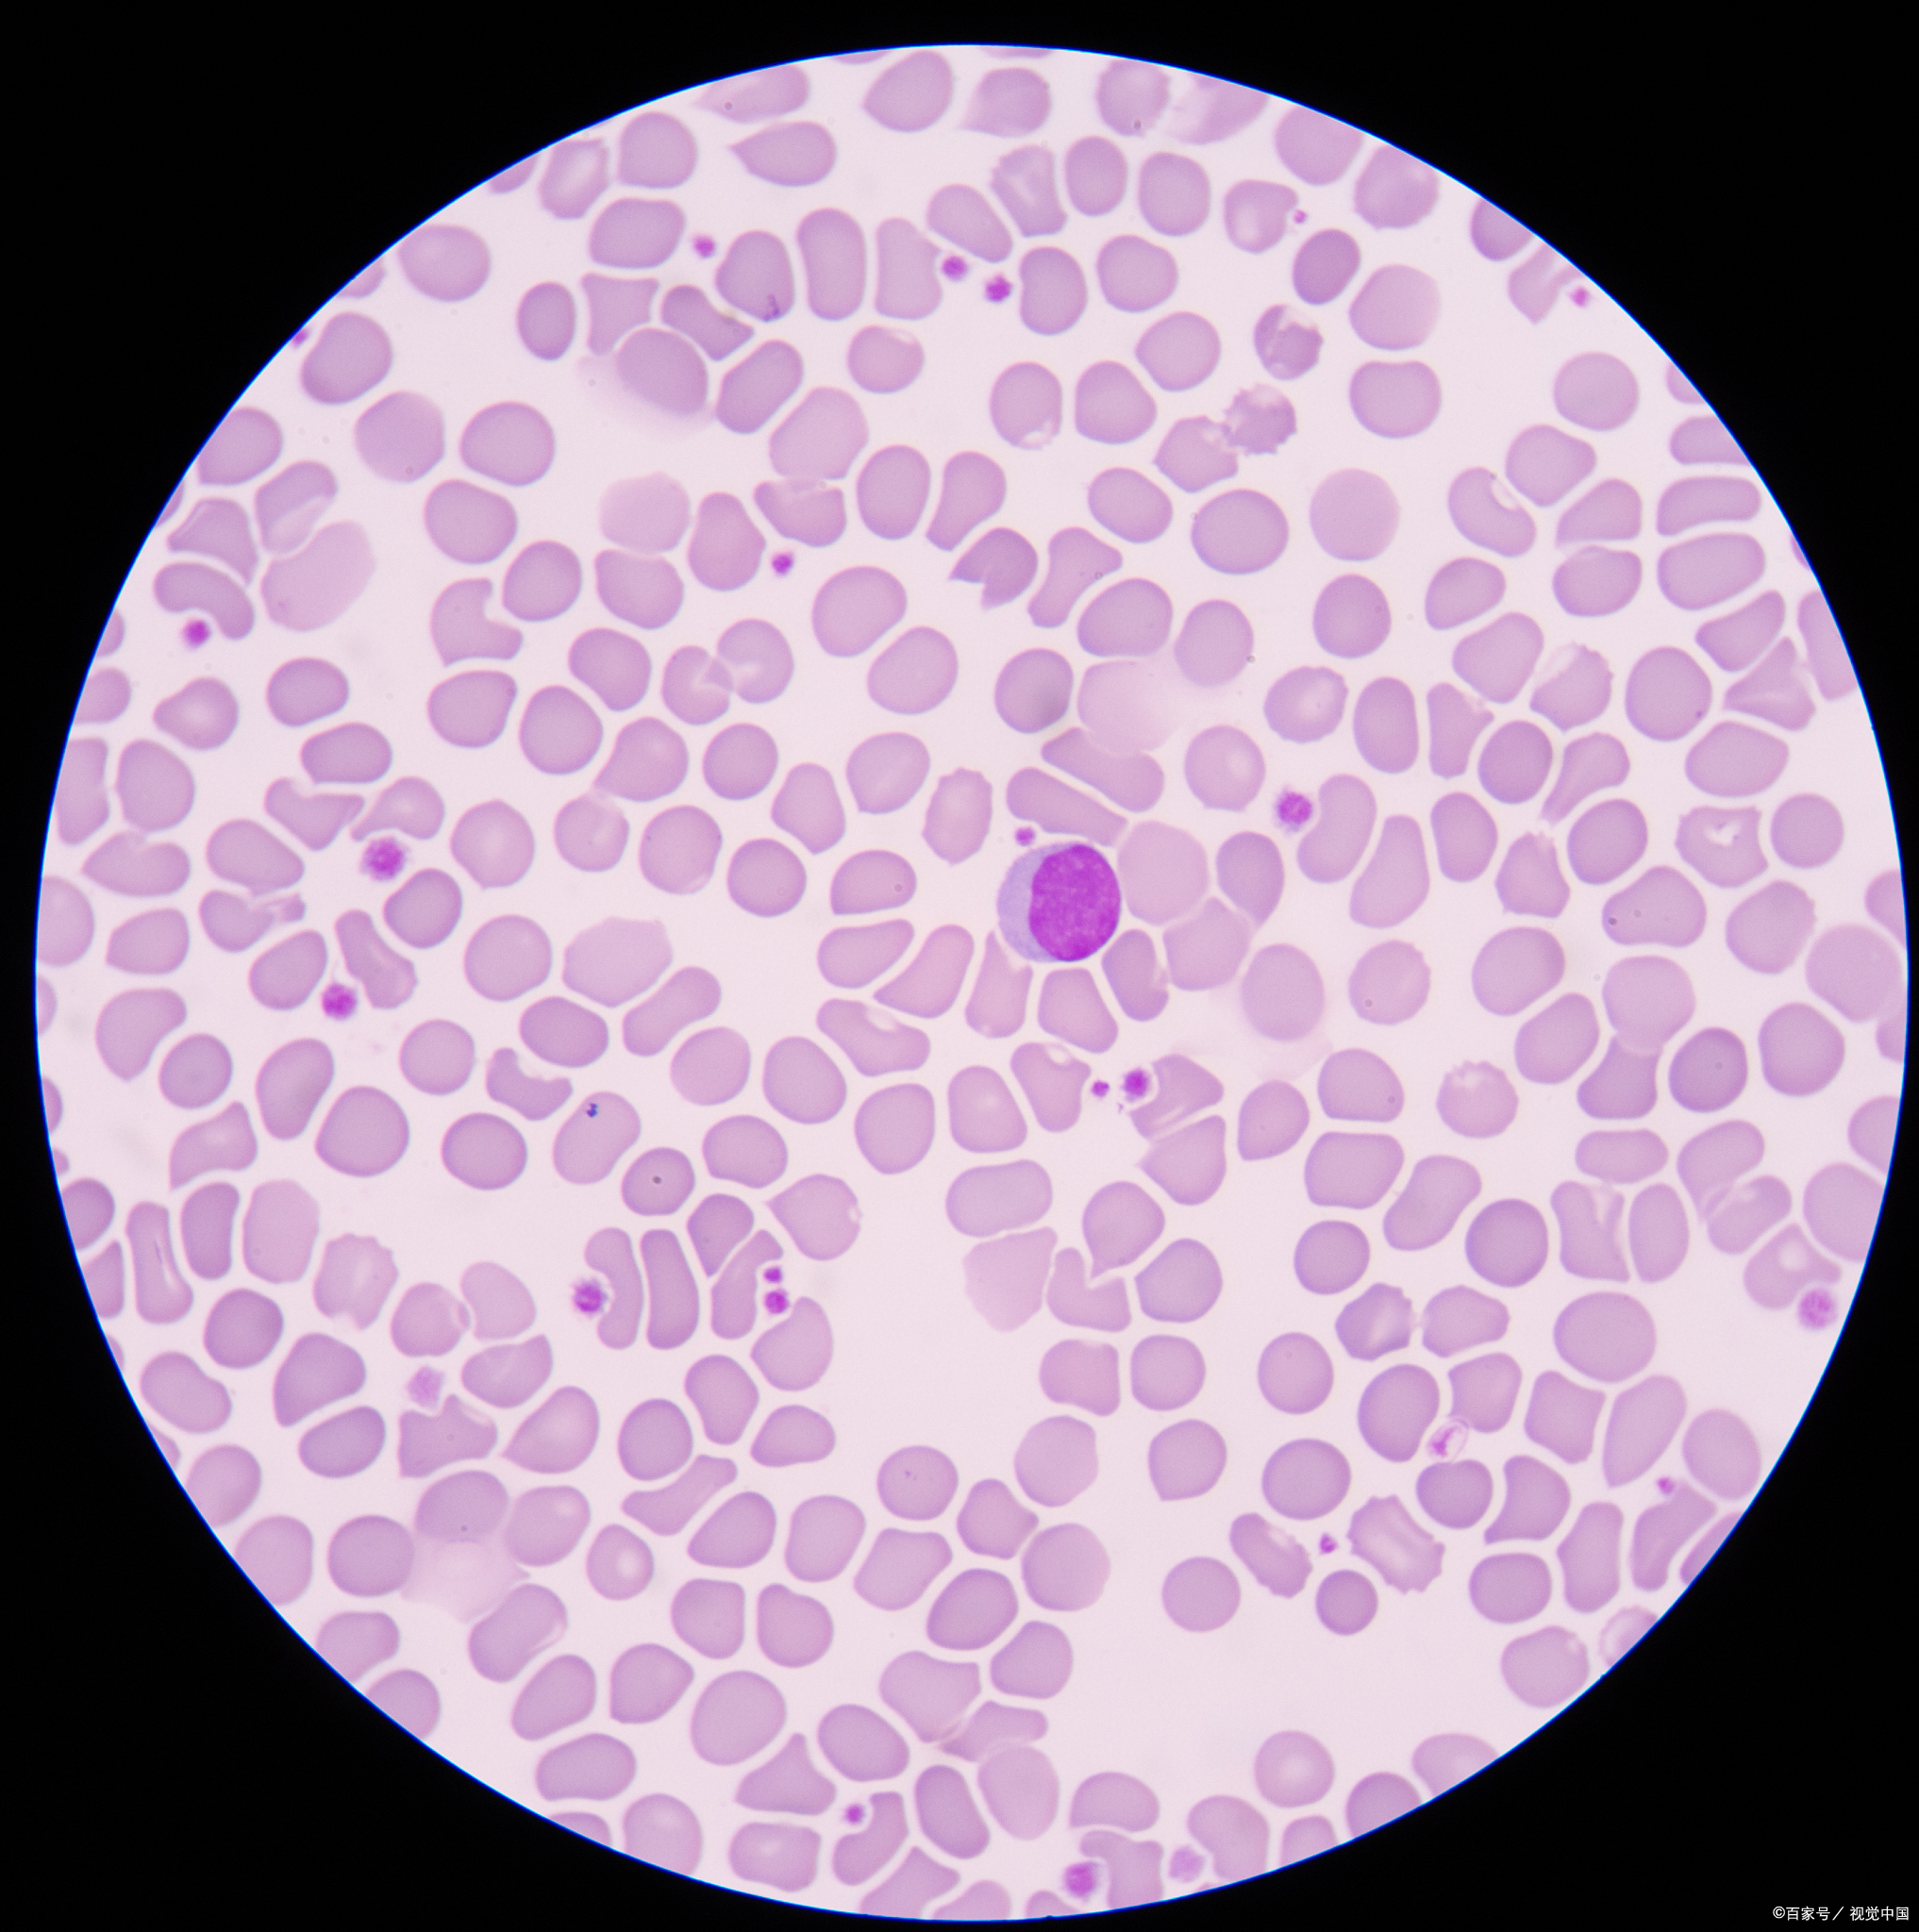

再生障碍性贫血aplastic anemia简称再障系多种病因引起的造血障碍,导致红骨髓总容量减少,代以脂肪髓,造血衰竭,以全血细胞减少为主要表现的一组综合征据国内21省市自治区的调查,年发病率为07410万人口,明显低于白血病的发病率慢性再障发病率为06010万人口,急性再障为01410万人口各年龄组均可发病,但。
用法2灵芝12~20克,煮沸后泡茶饮用适合高血压病慢性支气管炎消化不良神经衰弱白细胞减少再生障碍性贫血冠心病肝炎高血脂症糖尿病克山病肿瘤等多种疾病,可长期服用 用法3灵芝6克,甘草45克,用3碗水煎至1碗适用于神经衰弱高血压慢性肝炎等 用法4。
再生障碍性贫血atg治疗,除所有指标都正常外,病人如果面色红润,眼睛有神,记忆力强,反应迅速,运动灵活,心情饮食睡眠正常,这才算是真正治愈了。
个体差异不同患者的身体反应和恢复能力有所不同,这会直接影响骨髓移植后的存活时间年龄年轻患者通常具有更强的恢复能力和更高的存活率,而年龄偏大的患者可能面临更高的风险和更低的存活率疾病种类某些疾病如重型再生障碍性贫血的存活几率较高,而白血病等疾病的存活几率可能相对较低个人健康。
脐带血不仅能够自用,同时也能够给家人使用,并且配型成功率率相对较高脐带血治病救命的故事一直在我们的周边轮番上演,许多二胎宝宝用自己的脐带血救了一胎宝宝的病3岁的萱萱不幸罹患重型再生障碍性贫血,经过多次药物治疗始终没有好转幸运的是,2013年萱萱的弟弟降生了,父母为他在脐带血造血干细胞。
脐血有什么好处提供造血干细胞龙腾飞博士,中汉大学孙一仙纪念医院妇产科医生,说明脐血中丰富的干细胞是造血干细胞的重要来源,对白血病淋巴瘤再生障碍性贫血等重要疾病具有治疗作用此外,脐血在器官克隆组织器官衰老修复人体抗衰老治疗癌症神经脊髓损伤等方面也有一定的发展前景安全性高。
转载请注明来自极限财经,本文标题:《再生障碍性贫血存活率高吗》

京公网安备11000000000001号
京公网安备11000000000001号 京ICP备11000001号
京ICP备11000001号
还没有评论,来说两句吧...